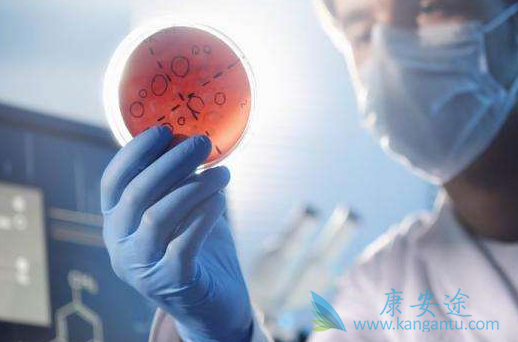

丙肝是有丙肝病毒引起的,严重时可以导致肝硬化,还有一部分的患者可能会发展成为肝癌。据统计,我国的慢性丙肝患者大约有450万人,但由于丙肝感染有一定的隐匿性,大部分的丙肝感染者并不清楚自己是否感染丙肝病毒。丙肝会传染吗?丙肝是会传染的,丙肝的传播途径与乙肝的相似,主要的丙肝的传播途径有四种。血液的传播是丙肝的传染方式之一,输血后肝炎70%以上是丙肝。我国自1993年对献血员筛查抗-HCV,2015年开始对抗-HCV阴性献血员筛查HCVRNA,经输血和血制品传播已很少发生。但是,在目前就诊的患者中,大多有1993年以前接受输血或单采血浆还输血细胞的历史。
丙肝的传播途径包括性传播,多个性伴侣及同性恋者属于高危人群;同时伴有其他性传播疾病者,特别是感染人类免疫缺陷病毒(HIV)者,感染HCV的危险性更高。经破损的皮肤和黏膜传播这是目前最主要的传播方式。包括使用非一次性注射器和针头、未经严格消毒的牙科器械、内镜、侵袭性操作和针刺等。在某些地区,因静脉注射毒品导致HCV传播占60%~90%。一些可能导致皮肤破损和血液暴露的传统医疗方法也与HCV传播有关;共用剃须刀、共用牙刷、纹身和穿耳环孔等也是HCV潜在的经血传播方式。

抗HCV阳性母亲将HCV传播给新生儿的危险约2%,若母亲在分娩时HCV RNA阳性,则传播的危险性高达4%-7%;合并HIV感染时,传播的危险性增至20%。HCV高载量可能增加传播的危险胜。接吻、拥抱、喷嚏、咳嗽、食物、饮水、共用餐具和水杯,无皮肤破损及其他无血液暴露的接触一般不传播HCV。但是在第八版传染病学有一条:生活密切接触传播:散发的HCV感染者中约40%无明确的输血及血制品注射史,称为社区获得性,其中的大部分由生活密切接触传播,建议辩证思考。
详情请访问 丙肝 https://www.kangantu.com/
















请简单描述您的疾病情况,我们会有专业的医学博士免费为您解答问题(24小时内进行电话回访)